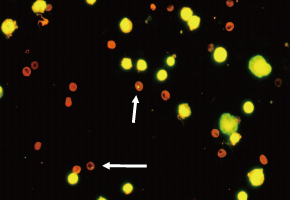
小核試験（骨髄）の写真

労働者健康安全機構 トップページ > 研究事業 > 化学物質等の有害性調査 > 試験に関する豆知識 >
小核試験の豆知識
小核試験は、従来、ほ乳動物に化学物質を投与し、その骨髄細胞(赤血球)における小核形成を指標として化学物質の変異原性を調べ、その潜在的がん原性をスクリーニングします。また、微生物を用いる変異原性試験(エームス試験)やほ乳類培養細胞を用いる染色体異常試験で変異原性が明らかでない場合の二次スクリーニング試験等としても有効な方法です。
ほ乳動物(げっ歯類)を用いる小核試験(骨髄)
|
一般的に実施されているのが、骨髄の幼若な赤血球中に出現する小核(写真中矢印)を調べる方法で、潜在的がん原性をスクリーニングします。 |
|---|
ほ乳動物(げっ歯類)を用いる小核試験(肝臓)
 |
多くの化学物質は体内に取込まれ、肝臓で代謝されてからがん原性を示すため、動物の肝臓で小核の誘発性を調べることは有用です。肝臓小核試験では、化学物質を投与し、肝臓の2/3を切除した後の再生肝実質細胞中に出現した小核(写真中矢印)を調べます。 |
|---|
ほ乳動物(げっ歯類)を用いる小核試験(皮膚)
 |
労働現場では、化学物質は主に呼吸によって体内に取込まれたり、皮膚について体内に取込まれたりします。その化学物質の吸収部位である皮膚での小核の誘発性を調べることは、また有用なことです。皮膚の小核試験では、動物の背中に化学物質を塗布し、皮膚上皮の分裂直後の細胞中に出現する小核(写真中矢印)を調べます。 |
|---|
ほ乳動物(げっ歯類)を用いる小核試験(精巣)
 |
体を構成している細胞は、骨髄の赤血球細胞、肝臓の実質細胞及び皮膚の上皮細胞などの体細胞と精子細胞及び卵子細胞の生殖細胞に分類されます。精巣の小核試験では、減数分裂後の精子細胞中に出現した小核(写真中矢印)を調べます。この試験は、化学物質の次世代に影響する遺伝毒性を評価する試験としても有効です。 |
|---|
ほ乳類培養細胞を用いる小核試験(in vitro小核試験)
 |
in vitro小核試験は、CHL/IU細胞(チャイニーズハムスター由来肺細胞)に化学物質を処理し、その培養細胞における小核形成(写真中矢印)を調べることにより、化学物質の潜在的がん原性をスクリーニングします。 |
|---|










